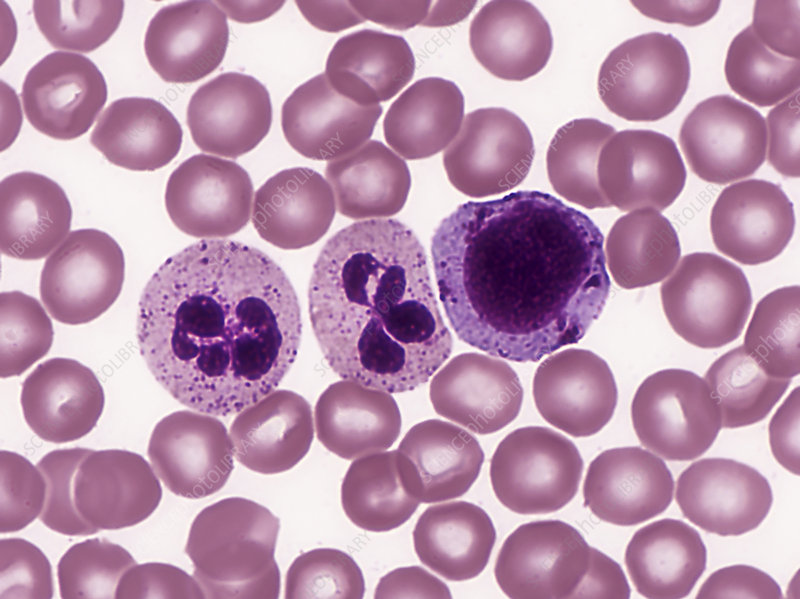
<p></p>

Transport system : structure and composition of blood
1/13
There's no tags or description
Looks like no tags are added yet.
Name | Mastery | Learn | Test | Matching | Spaced | Call with Kai |
|---|
No study sessions yet.
14 Terms
Describe the circulatory system
The circulatory system is a system of blood vessels with a pump and valves to ensure one-way flow of blood
Identify red and white blood cell in photomicrographs and diagrams
List the components of blood
55% plasma, the fluid part of blood.
45% is made up of blood cells and platelets.
State the function of red blood cells
Red blood cells transport oxygen around the body from lungs to cells which is required for aerobic respiration
State the function of white blood cells
Defend the body against infections by pathogens by carrying out phagocytosis and anti body production
State the function of platelets
Help blood clot
State the function of plasma
To transport carbon dioxide, digested food, urea, mineral ions, hormones and heat energy,